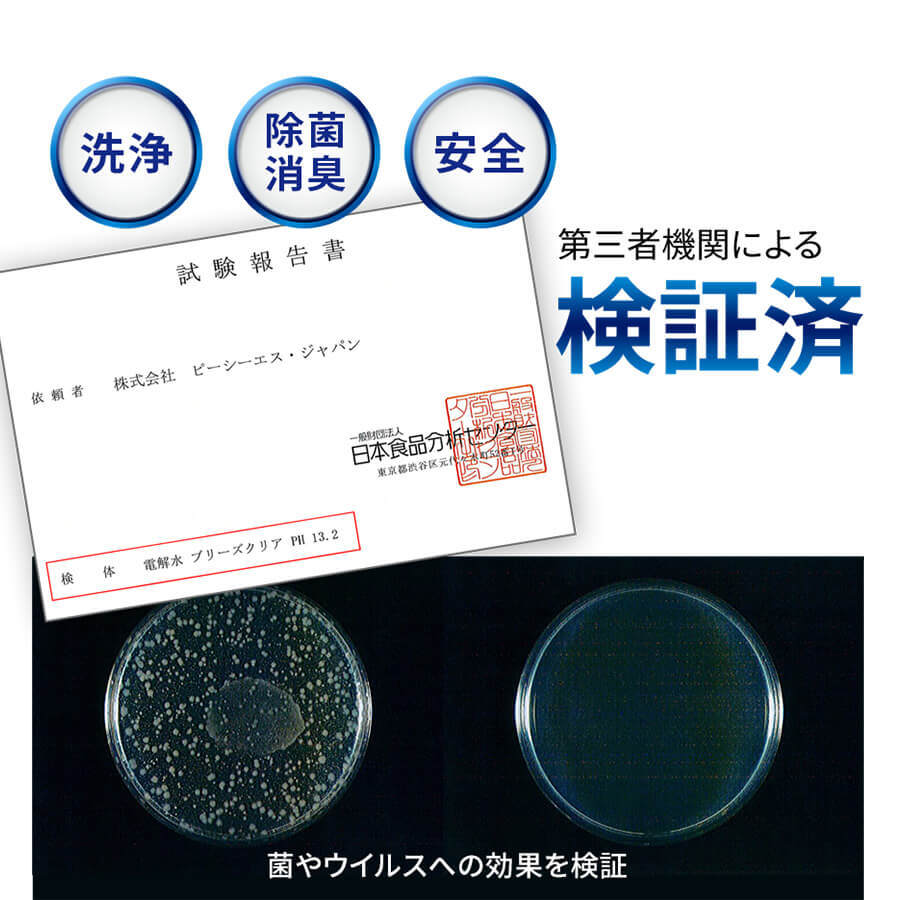
ブリーズクリア商品紹介

がんこな油汚れやたばこの汚れ等、酸性の汚れに強い
強アルカリ電解水のマルチクリーナー。二度拭き不要です。
ブリーズクリアは、水から生まれたマルチクリーナー。業界トップクラスのpH13.2は汚れを強力に落とし、酸性、たんぱく汚れに特に力を発揮します。あきらめていた換気扇やグリルの油汚れにぜひお試しください!
汚れを落とすだけでなく、除菌・消臭にもすぐれた効果があります。
ブリーズクリア125はpH12.5。原液のままで使えて日常のお掃除に便利。安心の界面活性剤、化学物質不使用。業務用におすすめです。
ブリーズクリア ph13.2
- 主成分
- アルカリ電解水100%
- 使用方法
- 用途に合わせて原液のまま、または希釈してお使いください。汚れの種類、度合いにより使い分けてください。
○直接スプレー後、ティッシュ・布等で拭き取る
○ティッシュ・布等に含ませて拭く
○つけ置き、またはパック
〈用途に合わせた希釈の例〉
○油汚れが特にひどい箇所 原液または約2倍(原液1:水1)
○換気扇やレンジ等の油汚れ、タバコのヤニ等 約3倍(原液1:水2)
○レンジ・オーブン・空調・流し台など一般的な汚れ 約5倍(原液1:水4)
○電化製品・テーブル・床・洗面台・ドアノブ 約15倍(原液1:水14)
○窓などのガラス製品 約50倍 (原液1:水49)
※ブリーズクリアは水に戻りますので二度拭きは不要ですが、ガラス製品に使用する場合は二度拭きすることできれいに仕上がります。
※人間の皮膚は酸性のタンパク質でできているため、直接アルカリ電解水をさわると肌荒れの原因にも。ゴム手袋を使用すると安心です。 - 使用用途
- ○油汚れが気になる箇所(レンジ周り・換気扇等)
○電子レンジ
○オーブン
○冷蔵庫
○空調
○流し台
○キーボード
○車の内部
○子供の玩具
○家具
○電化製品
○窓
○ペット用品等 - 保管について
- 日光の当たらない、温度差のない室内にて常温保管してください。
- 使用できないもの
- ○コーティング加工物は、コーティングが剥がれる可能性があります
【例】液晶ディスプレイ・PCディスプレイ・眼鏡・レンズ・ニス塗り家具・漆器・金箔・自動車塗装・フローリング(ワックス 施工)等
○水拭きできないものや水が染み込むものは後でシミになる恐れがあります
【例】白木・畳・大理石・自然乾燥工芸品・皮革類・ぬいぐるみ・シルク・カシミヤ等の獣毛製品等
○一部金属は変色する恐れがあります
【例】金・銀・銅・アルミ・真鍮・鉛・メッキ加工品等
○宝飾品は変色や変質の恐れがあります
【例】宝石類・貴金属等
○電気系統は水に濡れるとショートします
【例】電気配線・プリント基盤・配線部等
○その他 布製クロスのすす状の汚れ等
※こちらに記載がないものでも、使用の可否が不明のものや変色・変質等のご心配がある場合には、ご使用前に目立たない箇所でお試しください。 - コストパフォーマンス
- ブリーズクリアpH13.2は用途に合わせて希釈して使用できます。5倍に薄めればpH12.5に、15倍に薄めればpH12.0に調整できます。1本あたりの単価を考えますと、たいへんお安くお使いいただけます。
- 製造国
- 日本
- 商品サイズ
- 500mlスプレー / 2L / 4L / 20l /500mlスプレー×2Lセット
第三者機関による効果・安全性試験実施済
- ○除菌結果試験
第17127787001-0101号 日本食品分析センター調べ - ○急性経口毒性試験
第17127787001-0201号 日本食品分析センター調べ - ○皮膚一次刺激性試験
第17127787001-0301号 日本食品分析センター調べ - ○眼刺激性試験
第17127787001-0401号 日本食品分析センター調べ
品質保証
ブリーズクリアの保証期限については、製造から2年とさせていただいております。正しく保管していただければ、保証期限まで十分にご使用いただけますが、アルカリ電解水の性質上、開封後の保管期間が長くなりますと若干pH値は下がります。水で希釈したブリーズクリアは、できるかぎり早く使い切ってください。
使用上の注意
- ○飲料用ではありませんので飲まないでください。
- ○表記の用途以外には使用しないでください。
- ○肌の弱い方や長時間使用する場合、炊事用手袋などを使用してください。
- ○目に入った場合は、すぐに流水で洗い、専門医にご相談ください。
- ○万一飲み込んだ場合は水を飲み、専門医にご相談ください。
- ○人に向けてスプレーしないでください。
- ○幼児の手の届く場所には置かないでください。
- ○直射日光・高温・凍結するところには保管しないでください。
ブリーズクリア 125
- 主成分
- アルカリ電解水100%
- 使用方法
- 用途に合わせて原液のままお使いください。汚れの種類、度合いにより使い分けてください
○直接スプレー後、ティッシュ・布等で拭き取る
○ティッシュ・布等に含ませて拭く
○つけ置き、またはパック
※使用箇所により、希釈してもご使用いただけます。
※ブリーズクリアは水に戻りますので二度拭きは不要ですが、ガラス製品に使用する場合は二度拭きすることできれいに仕上がります。
※人間の皮膚は酸性のタンパク質でできているため、直接アルカリ電解水をさわると肌荒れの原因にも。ゴム手袋を使用すると安心です。
※生成過程で塩化ナトリウムは使用せず、炭酸カリウムを使用しているため、金属を腐食させることはありません。 - 使用用途
- ○レンジまわり
○換気扇
○電子レンジ
○オーブン
○冷蔵庫
○空調
○流し台
○キーボード
○車の室内
○子供の玩具
○家具
○電化製品
○窓
○ペット用品等
○幅広いお掃除に - 保管について
- 日光の当たらない、温度差のない室内にて常温保管してください。
- 使用できないもの
- ○コーティング加工物は、コーティングが剥がれる可能性があります
【例】液晶ディスプレイ・PCディスプレイ・眼鏡・レンズ・ニス塗り家具・漆器・金箔・自動車塗装・フローリング(ワックス 施工)等
○水拭きできないものや水が染み込むものは後でシミになる恐れがあります
【例】白木・畳・大理石・自然乾燥工芸品・皮革類・ぬいぐるみ・シルク・カシミヤ等の獣毛製品等
○一部金属は変色する恐れがあります
【例】金・銀・銅・アルミ・真鍮・鉛・メッキ加工品等
○宝飾品は変色や変質の恐れがあります
【例】宝石類・貴金属等
○電気系統は水に濡れるとショートします
【例】電気配線・プリント基盤・配線部等
○その他 布製クロスのすす状の汚れ等
※こちらに記載がないものでも、使用の可否が不明のものや変色・変質等のご心配がある場合には、ご使用前に目立たない箇所でお試しください。 - 製造国
- 日本
- 商品サイズ
- 2L / 4L / 20l
第三者機関による効果・安全性試験実施済
- ○急性経口毒性試験
第17127787001-0201号 日本食品分析センター調べ - ○皮膚一次刺激性試験
第17127787001-0301号 日本食品分析センター調べ - ○眼刺激性試験
第17127787001-0401号 日本食品分析センター調べ - 上記はブリーズクリアpH13.2で実証されています。より濃度が高いpH13.2での結果ですので、pH12.5も同様に安心してご使用いただけます。
品質保証
ブリーズクリア・125の品質保証期間(pH12.5以上を維持できる期間)は製造から1年とさせていただいております。pHは徐々に低下するため、1年経過後でも使えなくなるという事ではありませんのでご安心ください。開封後、空気に触れていくとpHの低下速度が早まりますので、しっかりキャップを閉めて保管しお早めにご使用ください。
使用上の注意
- ○飲料用ではありませんので飲まないでください。
- ○表記の用途以外には使用しないでください。
- ○肌の弱い方や長時間使用する場合、炊事用手袋などを使用してください。
- ○目に入った場合は、すぐに流水で洗い、専門医にご相談ください。
- ○万一飲み込んだ場合は水を飲み、専門医にご相談ください。
- ○人に向けてスプレーしないでください。
- ○幼児の手の届く場所には置かないでください。
- ○直射日光・高温・凍結するところには保管しないでください。